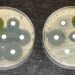

أدوية حب الشباب قد تفضي للانتحار
نبه علماء إلى ضرورة مراقبة الشباب الذين يعانون من تزايد حدة حب الشباب لديهم، حيث إن الحالة يمكن أن تجعلهم يفكرون في الانتحار وفي بعض الحالات قد تسوء حالاتهم بسبب استخدام الأدوية المضادة لحب الشباب.
وأفادت الدراسة التي أوردتها صحيفة غارديان ونشرت في المجلة الطبية البريطانية اليوم بأن عقاقير مثل إيسوترتينيوين تقلل خطر الانتحار في بعض الشباب، كما أنها تحسن مظهرهم. لكن بالنسبة لبعض المرضى الضعفاء قد يحفز إسوترتينيوين هذا السلوك.
ووجد الباحثون في معهد كارولينسكا بالسويد أن خطر الانتحار زاد في السنة التي سبقت تناول المريض للدواء. وقالوا إن هذا دليل واضح على أن حب الشباب الحاد يشكل في حد ذاته خطر الانتحار. لكن الدليل ليس بهذا الوضوح في أي دور لعبه الدواء.
وأضافوا أن المرضى أن الذين لم يتأثروا إيجابيا بالعلاج ربما يكونون فقدوا الأمل في احتمال الاستمرار في العيش مع تشوهات حب الشباب. ولم يستبعد الباحثون أيضا احتمال أن المرضى الذين توقعوا تحولا في حياتهم بعد العلاج ربما شعروا باضطراب شديد عندما لم تتحسن حياتهم الاجتماعية.
لكن إذا أمكن تعجيل الانتحار في بعض الناس بواسطة الدواء فإن الدراسات المستقبلية يجب أن تحاول استنباط أي المرضى أكثر عرضة للخطر.
وكتب الباحثون أن الأهم من ذلك هو الحقيقة بأن محاولات الانتحار يمكن أن تحدث بعد فترة طويلة من توقف العلاج. ولهذا السبب فإن الرصد الدقيق للحالة العقلية للمرضى الذين يتناولون إيسوترتينيوين، فضلا عن أولئك الذين يعانون من حب الشباب الحاد، يجب أن يكون جزءا من عملية العلاج وينبغي أن يستمر لما لا يقل عن سنة بعد انتهاء العلاج.
وقالت الدكتورة سارة بيلي، وهي محاضرة بقسم الصيدلة وعلم الأدوية في جامعة باث البريطانية، إن البحث مهم لأنه يعزز الرأي بأن حب الشباب نفسه يمكن أن تكون له تأثيرات نفسية خطيرة وهناك خطر انتحار ضئيل لبعض المرضى بحب الشباب.
وأضافت أن قضية خطر الانتحار المتزايد المثيرة للجدل بسبب استخدام إيسوترتينيوين لم يتم التوصل إلى حلها في البحث المذكور، وهذا ما يعترف به الباحثون أنفسهم.